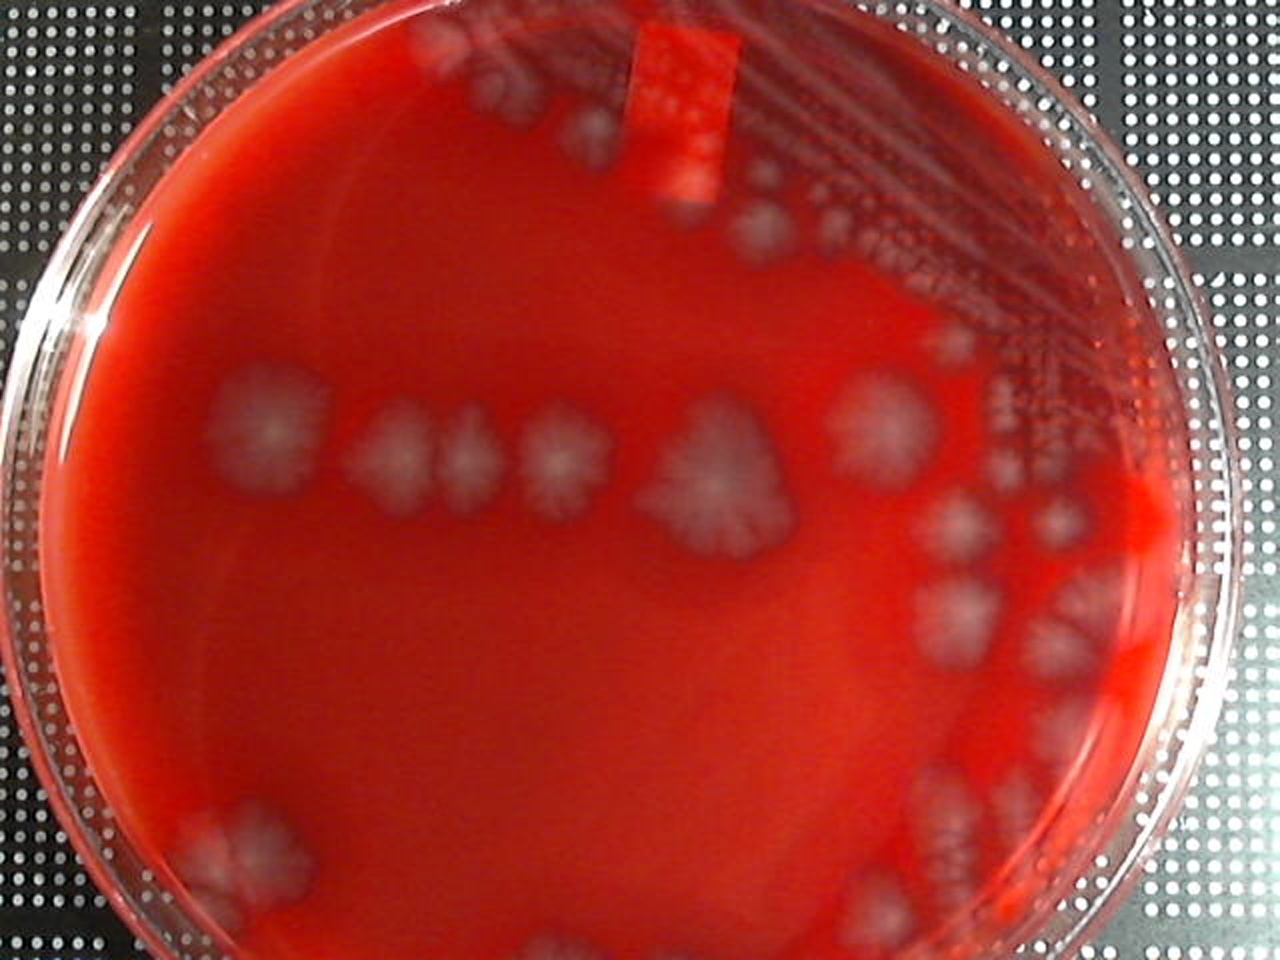

Clostridium
Clostridium perfringes

Incubation: Anaerobic
Media: Anaerobic Blood Agar
Source: Stool
Colony Morphology
Form: Irregular
Elevation: Raised
Margin: Lobate
Color: Gray
Special Characteristics: Swarming
Hemolysis — Beta
Gram Stain
Gram Positive
Microscopic Morphology: Bacilli
Organism Size: Large
Testing Pathways — None needed!